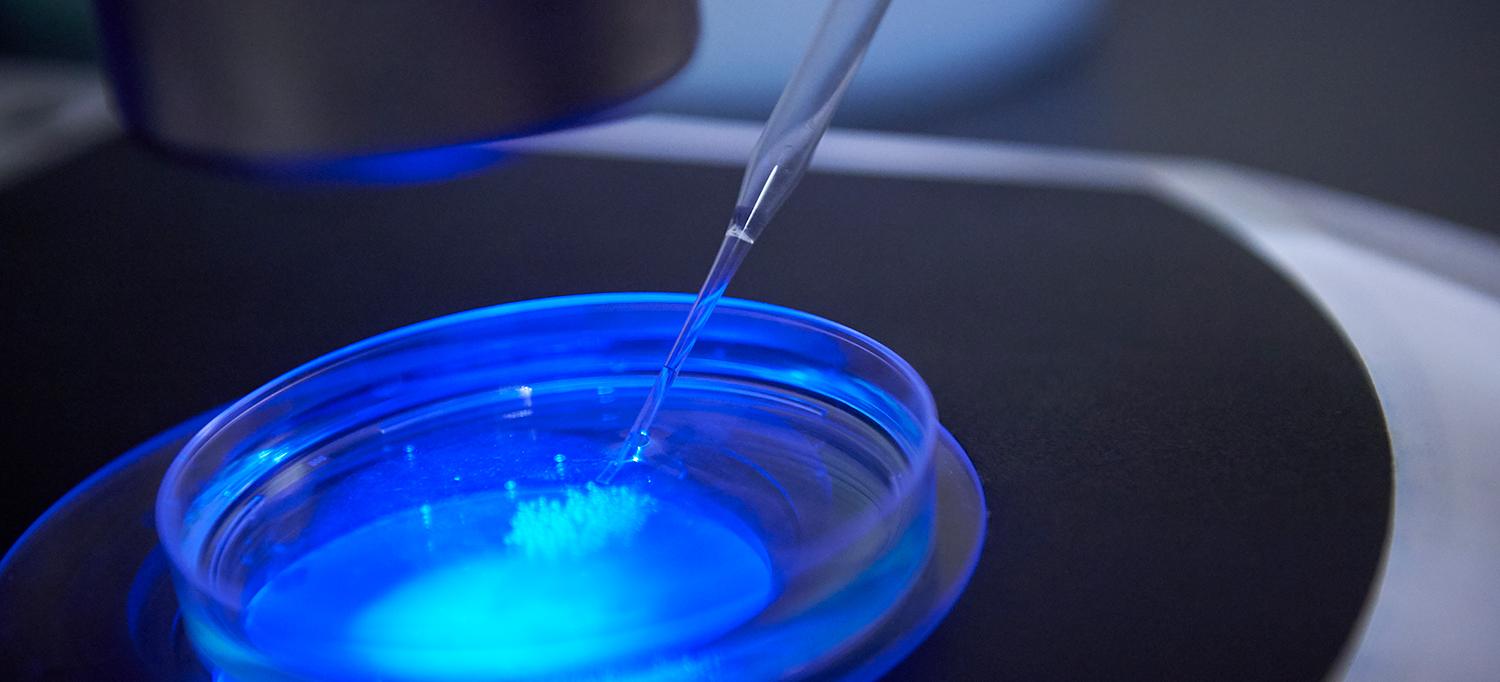

Photo: Juliana Thomas
As director of cancer biologics at NYU Langone Health’s Perlmutter Cancer Center, Shohei Koide, PhD, a professor in the Department of Biochemistry and Molecular Pharmacology, and his colleagues develop cancer therapies and innovative tools to investigate the biology of cancer.
The central goal of Dr. Koide’s research effort is to control biology at molecular levels using synthetic, or human-made, proteins. Using a “learning by building” approach, he and his colleagues advance the understanding of principles that govern protein structure, function, and evolution, with the goal of developing novel synthetic proteins, including therapeutic drugs.
Dr. Koide discusses how he and his colleagues take discoveries from the laboratory and translate them into potential drugs, his research on antibodies to coronavirus disease (COVID-19), and more.
Tell us about your work as director of cancer biologics at Perlmutter Cancer Center.
My role as director of cancer biologics is to translate early discoveries at the cancer center into prototypical drugs. Most of the initial discoveries are made at the gene level. For example, let’s say a colleague finds a gene whose product is more abundant (upregulated) or which is changed (mutated) in a particular cancer, which leads to a hypothesis that a therapeutic targeting that particular gene may be potentially useful. My role is to translate that initial discovery into the language of protein science first because most drugs work by attacking the protein encoded by the gene and not the gene itself. We study the functions and shape of the protein. The second step is to translate that knowledge into a therapeutic strategy and then develop molecules in the form of synthetic proteins, particularly antibodies, that can hit an important part of the target protein. Finally, in close collaboration with the colleague, we then determine whether our molecules actually produce a desirable outcome.
What are some of the early discoveries that your team has developed into therapeutic strategies?
The most advanced program is a monoclonal antibody called LYT-200. Originally that program started from a discovery made by a former Perlmutter Cancer Center collaborator, who showed that a molecule called galectin-9 is upregulated in solid tumors including pancreatic cancer and colorectal cancer and is associated with poorer survival outcomes in people who have cancer. Original work conducted in mice showed that genetically depleting galectin-9 has favorable outcomes. We produced designed versions of galectin-9 proteins in our own lab and, using our synthetic protein discovery pipeline, we developed a monoclonal antibody that hits a particular spot in galectin-9. LYT-200 is a human antibody that is designed to bind galectin-9 molecules from humans, monkeys, rats, and mice equally well, a particularly useful feature for rapid clinical translation.
A company called PureTech Health is now evaluating LYT-200 in a phase 1 clinical trial for the potential treatment of metastatic solid tumors. With LYT-200, we are trying to address an unmet need, particularly in solid tumors. We know that immunotherapy is changing cancer therapy quite dramatically, but many tumor types are still not responsive to current immunotherapies, such as anti–PD-1 and anti–PD-L1. Cancers are smart, and they have many ways to suppress our own immune systems, and galectin-9 is one of them. By inhibiting the immunosuppressive function of galectin-9 with LYT-200, we are hoping to potentiate, or increase, the immune system’s ability to attack difficult tumors by itself as well as in combination with other therapies including immunotherapies.
LYT-200 is the most advanced molecule, but we have several other programs that are progressing rapidly. Two programs that are conceptually related to LYT-200 aim to either potentiate the immune system for cancer therapy or to dampen the immune system for treating autoimmune diseases. We also have two targeted therapy programs for leukemia that aim to selectively deplete leukemia stem cells. In each program, we employ similar therapeutic design strategies to different protein targets. I am excited that we are advancing these “made at Perlmutter Cancer Center” therapeutics from team-based discoveries.
Can you tell us about your work on COVID-19?
Our research focus is to produce antibodies and other biologics for cancer research, and in the course of these activities, we do a lot of antibody characterization. When COVID-19 came about, we devoted our lab to help characterize antibody responses, or serology, against COVID-19 using our expertise in antibody characterization. We quickly set up a new method to comprehensively profile antibodies against different parts of the spike protein. We are now working with NYU Langone’s Vaccine Center as well as the Departments of Microbiology, Pathology, and Population Health to look at how COVID-19 antibodies develop after COVID-19 infection. We are starting to profile how the new mRNA-based vaccines stimulate anti–COVID-19 responses.
As you might expect, we utilized our discovery pipeline to develop a large panel of human synthetic antibodies against different parts of the viral spike protein, including potent neutralizing antibodies. Although we don’t intend to advance these antibodies as antiviral therapeutics, they have served as crucial tools in our discovery of a clever molecular mechanism that the virus employs to evade immune attacks.

